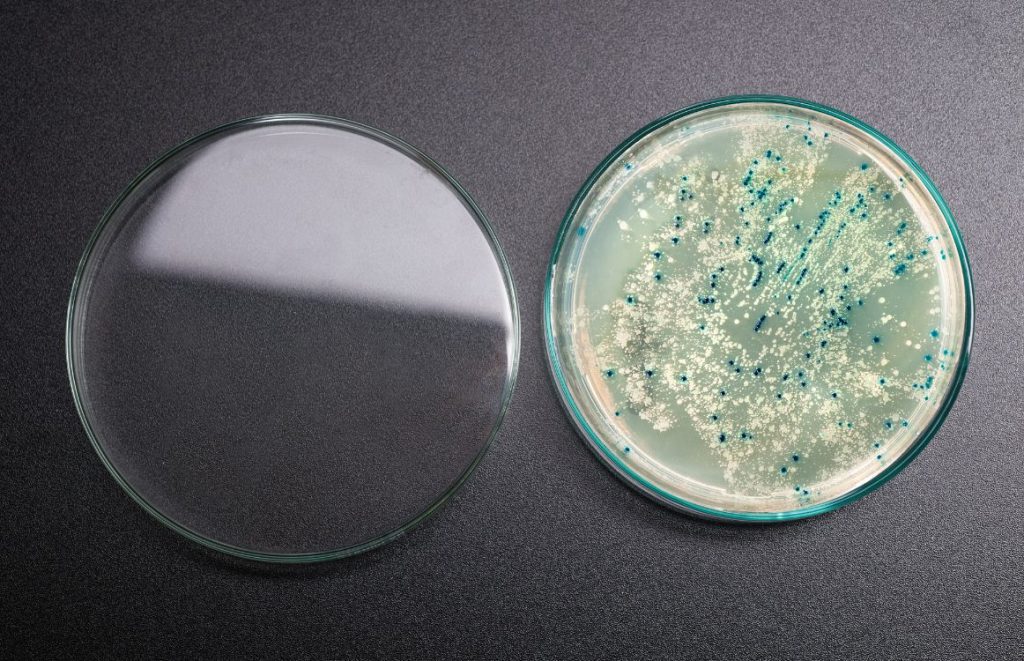
مقاومت آنتی بیوتیکی: راه های تشخیص باکتری مقاوم

روز جهانی هاری; ۲۸ سپتامبر ۲۰۲۵
هاری یکی از قدیمیترین و مرگبارترین بیماریهای ویروسی مشترک بین انسان و حیوان است که سالانه جان هزاران نفر را در سراسر جهان میگیرد. در ایران نیز هاری همچنان یکی از بیماریهای مشترک مهم بین انسان و حیوان به شمار میرود، بهویژه در مناطق روستایی و مرزی که تماس انسان با حیوانات ولگرد بیشتر است. …